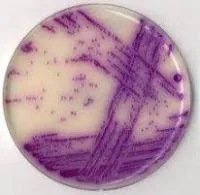

Nutrient chemical mediain Ulytau region
35 205 KZT
preorder
Питательная среда №2 ГРМ Сабуро
QazBioHim Industries
Almaty
Питательная среда №2 ГРМ (Сабуро) Набор реагентов для контроля микробной загрязненности (для выращивания грибов) Питательная среда №2 (Сабуро) предназначена для выращивания и подсчета общего числа дрожжевых и плесневых г...

30 532 KZT
preorder
Среда Бликфельдта-1
QazBioHim Industries
Almaty
Среда Бликфельдта-1 Среда Бликфельдта предназначена для выявления молочнокислых микроорганизмов в пищевых продуктах и кормах для животных (модификация 1 и модификация 2) и их подсчета (модификация 2), а также для выяснен...
41 900 KZT
preorder
Среда ПБЛ
QazBioHim Industries
Almaty
Среда ПБЛ Набор реагентов для бактериологических исследований "Питательный бульон для выделения листерий (среда ПБЛ)" предназначена для выделения листерий из клинического материала и пищевых продуктов при бактериологичес...
|
|
2009-2025 © All Rights Reserved
|